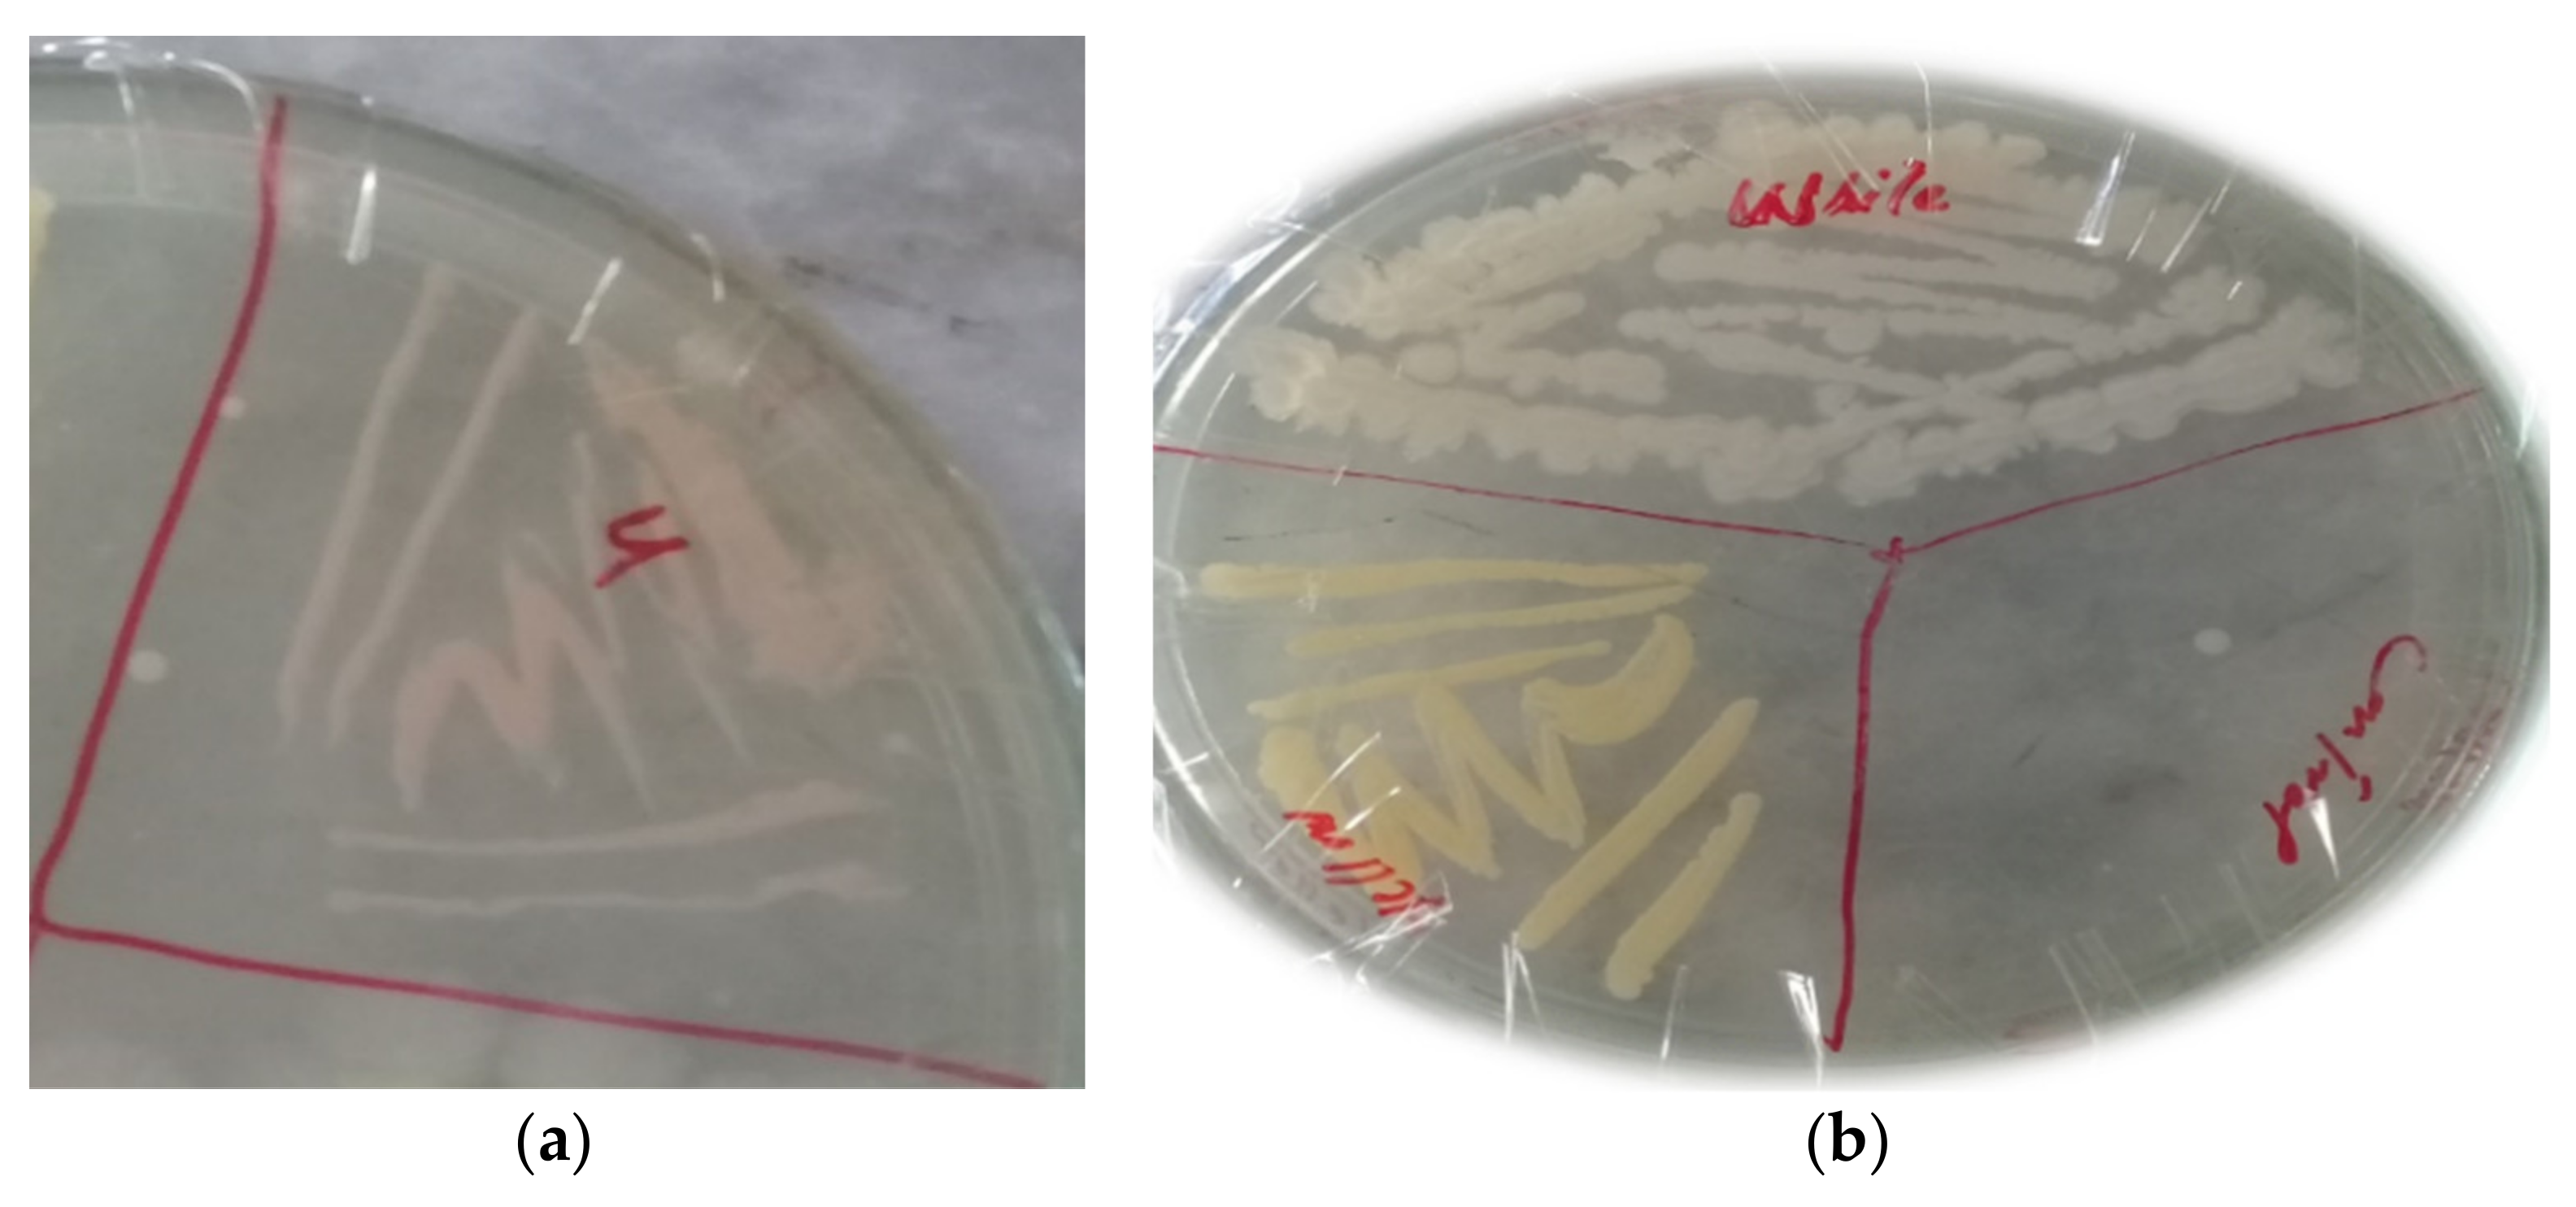
Animals 11 01843 g003 550

1. Introduction
Gastrointestinal parasites are considered as the main cause of economic losses in the livestock sector. Among gastrointestinal parasitic infections, haemonchosis is important and dominant that greatly destroys livestock production, particularly the small ruminants [
1]. This disease is caused by three species of the genus Haemonchus, namely,
H. similis,
H. placei, and
H. contortus. Among these,
H. contortus is one of the most prevalent nematode parasites that infect the abomasum of small ruminants worldwide [
2]. It is commonly known as a red stomach worm, the wire worm, or the barber’s pole worm. It belongs to phylum Nematoda, family Trichostrongyloidae, class Secernentea, and the order Strongylida. The highly susceptible part of ruminant’s stomach to
H. contortus is the abomasum, in which adult worms are present. This parasite causes low production, decreased growth, lower body weight, and sometimes, cause the death of the infected host. This parasite is most prevalent in Africa; however, many cases have been reported in North America as well [
3].
Haemonchus contortus mostly affects young animals, having hypo immunological response, showing low resistance to the parasite [
4]. Primary symptoms of haemonchosisinclude pallor, anemia, edema, ill thrift, lethargy, and depression, which may cause sudden death in acute infection. Another prominent symptom of haemonchosis is the accumulation of fluid in the submandibular tissue, a phenomenon commonly called “bottle jaw” [
5]. When the L3 larvae resume development in spring, the threat of haemonchosis increases. The young and pregnant or lactating mothers are highly susceptible to
H. contortus, because of their low immunogenic response against the parasite infection [
6]. A heavy infection (20,000–30,000 worms) of Haemonchus species can kill sheep and goats very quickly [
7]. Haemonchosis can be diagnosed based upon the characteristic clinical signs of anemia, low Packed Cell Volume (PCV), pale mucous membranes dehydration, weakness, retarded growth, and edema. [
8].
Haemonchus contortus is distributed throughout the world, where warm and humid climate prevails; hence, haemonchosis is a major threat in tropical and subtropical regions. [
9]. Haemonchus species are prevalent in Pakistan and are reported almost from every district of Pakistan by different researchers with varying percent prevalence [
10,
11,
12]. In Khyber Pakhtunkhwa and central Punjab, 72% prevalence of
H. contortus was reported, while other researchers recorded its prevalence with varying percentages in many districts of Pakistan [
13,
14,
15].
It is not advisable to eliminate the parasites from livestock, but to keep the population under a threshold, in a sustainable state [
16]. To control the nematode parasites, different management practices, such as the use of chemical anthelmintics, sanitation, vaccination, various plant extracts, and biological control, are in common practice [
17]. The helminths infection in man and animals is mostly treated by chemotherapy. Gastrointestinal nematode infections can be managed by using chemical anthelmintics, which are used as prophylactic measures. Due to the over-use of chemical anthelmintics, they reduce their effectiveness and emerge resistance in nematodes [
18]. The
H. contortus infection can also be effectively treated with the wire particles of copper oxide (COWP) and copper sulfate (CuSO
4). Using copper oxide wire particles 2.5 g to 5 g in sheep,
H. contortus eggs number was significantly reduced. These anthelmintics have been found to reduce the parasite population in small ruminants with low resistance development. Presently, it is used along with chemical antihelmintics to combat resistance development in
H. contortus [
19].
Limited information available regarding the anthelminthic activity of bacteria antagonists against parasitic nematodes. Some species, including
Bacillus sp., have been reported to have nematocidal activity. A soil bacterium,
Bacillus thuringienisis, is widely used as a biological control agent against different pathogens because of its low mammalian toxicity and the species specificity by particular endotoxin groups [
20].
Bacillus sp. Produce a variety of toxic proteins that are vigorous against different parasites [
21]. A number of toxins produced during vegetative growth show lethal activity; however, this lethal activity mainly results from the production of delta endotoxin that is synthesized during sporulation [
22,
23]. The production of other factors that might contribute to the toxic effects observed, such as proteases, chitinase, exotoxins, and lipases [
24].
Little is known about the microbial diversity in the abomasum of the sheep, an important site of nematode infection, and the correlation between the microbial diversity and GIN resistance. Thus, this work aimed to isolate bacteria from the abomasum of sheep and goats to test the anthelmintic activity of metabolites of these bacterial isolates against H. contortus.
2. Materials and Methods
The present research work was carried out in the Department of Microbiology, Kohat University of Science and Technology Kohat. All the processes were performed in the aseptic environment.
2.1. Collection of Abomasal Content and Fecal Samples
Abomasum content, as shown in
Figure 1a–c, was collected from slaughtered goats and sheep at a slaughterhouse in Kohat, Pakistan. A total of 50 samples of the abomasum and 50 samples of feces were taken from goats and sheep, and the samples were brought to Microbiology Laboratory for further processing.
2.2. Isolation and Identification of Bacteria from Abomasal Contents
Bacteria were isolated by serial dilution method, taking abomasal fluid in 100 mL of distilled water. After that, 1 mL from the suspension was taken and put in a test tube containing 9 mL of distilled water. Different bacterial dilutions 10
−1–10
−6 and sterile distilled water (control) were used. Streaks were made from 10
−3, 10
−4, 10
−5, and 10
−6 bacterial dilutions on petri dishes containing nutrient agar. The plates were incubated at 37 °C for 24 h. The bacterial isolates were subcultured and identified by colony morphology and biochemical tests, and finally, through genomic DNA sequencing [
25].
2.2.1. Colony Morphology
Size, shape, colony consistency, margins, and elevation are included in the colony morphology.
2.2.2. Gram Staining
Smear from each bacterial isolate was organized on a glass slide, and it was heat-fixed by passing it over the flame. Crystal violet was added drop by drop on the smear and left for 60 s. The slide was washed with tap water. For 45 s, iodine was overlaid on the slide and washed with distilled water. The slide was washed for 10 to 15 s with a decolorizer (alcohol). Smear was rinsed for few seconds with distilled water and counter-stained with safranin and air-dried. Deep violet or purple color emerged for Gram positive bacteria, while Gram negative bacteria appeared purple or red.
2.2.3. Biochemical Characterization of the Bacterial Isolates
For the identification of bacterial isolates, various biochemical tests were performed, such as Oxidase test, Indole test, Sugar fermenter test, Motility test, Catalase test.
Catalase Test
A drop of hydrogen peroxide was added to a slide. A loop filled with each of the bacterial isolates was mixed into the droplet. Bubble formation indicated a positive catalase test.
Oxidase Test
A smooth filter paper was put on a petri plate, and a drop of oxidase reagent was added. Bacterial culture was stretched on the droplet of the oxidase reagent, using an inoculating loop. The formation of the reagent’s dark purple color confirmed the oxidase positive test [
26].
Indole Test
Bacterial colonies were inoculated into individual tubes of 2 mL tryptone water, incubated at 37 °C for 24 h, and tested for indole production with Kovac’s reagent. If the reagent showed a cherry red color layer, then it confirms the positive test.
Sugar fermenter
The sugar fermentation test was performed by inoculating a loop full of a nutrient broth culture of the organisms into the tubes containing different sugar media (five basic sugars, such as dextrose, sucrose, lactose, maltose, and mannitol) and incubated for 24 h at 37 °C. The sugar fermenter was shown by a color change from reddish to yellow and the formation of gas bubbles in the inverted test tubes.
Motility Test
One drop of bacterial culture, grown on nutrient broth, was placed on the coverslip. The same was placed inverted over around the concave depression of the hanging drop slide to make hanging drop preparation and sealed with Vaseline to prevent airflow and evaporation of the fluid. The hanging drop slide was then examined under 100× objective of a compound microscope using immersion oil. The motile and nonmotile organisms were identified by observing motility with to and from the movement of bacteria [
27].
2.3. Isolation of Haemonchus Contortus Adults and Larvae from Abomasum
The abomasum of the freshly slaughtered goats and sheep were taken to pick adult H. contortus and larvae in the slaughterhouse of Kohat district, Pakistan. The worms were collected from the abomasum by washing with distilled water, and it was transferred into Phosphate Buffer Saline (PBS) with pH 7.4. The PBS was prepared by dissolving 8 g NaCl, 0.2 g KCl, 1.44 g Na2HPO4, and 0.24 g of KH2PO4 in 800 mL of distilled water, and distilled water was added to adjust the volume to one litter.
2.4. Isolation of H. contortus Eggs from Faecal Sample
In a petri plate (
Figure 2), about 4 g of feces were taken, and 60 mL floatation liquid was poured into the container by mixing feces carefully with a moving device. The resultant fecal suspension was poured over a filter of 200 µm into another vessel. The fecal contents were poured into a test tube. Then the test tube was topped gently with the interruption, a curved meniscus was formed at the top of the tube and placed a coverslip carefully. After 20 min, the droplet of liquid sticks to it. Under 10× and 40× of the compound microscope, the slides were observed [
28].
2.4.1. Estimation of Eggs in the Fecal Samples
The eggs of
H. contortus in the animal’s fecal samples were calculated by using the McMaster counting chamber method [
29]. In this procedure, Fresh feces of 3 g were taken and mix them in 42 mL of saturated sodium chloride solution. Through a tea filter or strainer, passed the suspension three times. Then both compartment of the McMaster counting chamber was filled with suspension and wait for 3–5 min and observed the McMaster chambers under the 10× of a light microscope.
Eggs seen in 1st and 2nd chambers were calculated as:
The nematode eggs were taken from the feces of sheep and goats. Eggs from the highest EPG were isolated by dissolving 5 g of feces in 10 mL of distill water. The diluted feces were filtered through a 100 mesh and transferred into another flask. Then the saturated salt solution was added into filtrate in the threefold volume of the flask. On top of the container, placed a clear plastic sheet; hence, the surface of the solution could touch the plastic sheet and placed it for 60 min. The eggs were adhered to its lower surface, and it was carefully washed away by tap water in a clean container. By removing the upper layer of the water, the eggs were settled down at the end of the container after one hour [
30].
2.4.2. Culture Filtrate Collection from the Bacterial Isolates
The nutrient broth, containing 0.5% Peptone and 0.3% beef extract/yeast extract in distilled water, was autoclaved, and inoculated with bacterial isolates, and incubated in a shaking incubator at 37 °C for 7 days. The broth culture was centrifuged at 1000 rpm for 15 min. The pellet was discarded. With the help of Whatman filter paper, the supernatant was filtered and again filter through Miller HA syringe filters (pore size = 0.45 µm). The secondary metabolites were obtained. To check the presence of bacterial cells in metabolites, it was again inoculated on nutrient agar plates at 37 °C for 24 h. Extract of metabolites were mixed with phosphate buffer saline and distilled water to make different concentrations.
The extracts were considered as 100% concentrated, while the bacterial extracts with PBS and anthelmintic agent were considered as a positive control (PC), whereas only PBS and worms were considered as a negative control (NC).
2.5. In Vitro Bioassays
Various concentrations of the bacterial culture filtrates were used to evaluate their anthelmintic effect on adult and larval mortality and egg hatch inhibition of
H. contortus, by using the standard techniques as per the protocol of Kotze [
20].
2.5.1. Adult Mortality Assay (AMA)
Adult worms were taken from the abomasum of freshly slaughtered sheep and goats to perform the adult mortality assay (AMA). Culture filtrate, obtained from three bacterial isolates Abomasum Bacteria with Pinkish Colony (ABP), Abomasum Bacteria with Yellow Colony (ABY), and Abomasum Bacteria with Creamy White Colony (ABCW), were diluted in PBS, as 100%, 50%, 25%, 12.5%, and 6.25% in 48 well plates, into which five adults’ nematodes were transferred into each well. The treatments were repeated five times. The bacterial culture filtrates were taken alone with worms, were considered as a 100% concentrated. For negative control, PBS with worms was used, whereas, for positive control, levasole (AgriLabs) 25 µg/mL in PBS with worms was used. Data on the adult nematode mortality were taken after every hour of the treatment, until all the worms were found dead in control. The treated worms were placed in warm PBS and observed their possible motility [
31].
The percent nematode mortality was calculated by the following formula:
P test: number of dead worms
P total: number of dead worms + number of live worms
2.5.2. Larval Mortality Assay (LMA)
Larvae (L3) of
H. contortus were taken from the abomasum of freshly slaughtered sheep and goats to perform the Larval Mortality Assay (LMA). Various concentrations of the bacterial metabolites (100%, 50%, 25%, 12.5%, and 6.25%) were prepared in PBS. The concentration was considered as 100% with L3 larvae and with metabolites. Well containing larvae and 2.5 mL phosphate buffer saline were considered as a negative control. The larvae to which an antihelmintic agent of 2.5 mL levasole (25 µg/mL) was added, considered as a positive control. The plates were placed in an incubator for 3 h at 37 °C. Under 10× of a stereo microscope, data on the larvae mortality were taken after three hours of treatments, until all the larvae were found dead in control. The treated worms were placed in warm PBS and observed their possible motility [
32].
The percent larvae mortality was calculated as:
P check: number of dead larvae
P total: number of dead larvae + number of live larvae
2.5.3. Egg Hatch Inhibition Assay
Egg hatch inhibition assay was performed to evaluate the inhibitory effect of the metabolites of the bacterial isolates ABP, ABY, and ABCW. This assay was repeated in triplicate following the protocol given by Coles et al. [
33].
Nematode eggs were placed in 15 mL of sterile distilled water, and by the McMaster technique, their quantity was adjusted to 100–200 eggs in 75 µL of water and was added into each well of a 24 well titration plate. Metabolites of each bacterial isolates were added to each well at various concentrations of 100%, 50%, 25%, 12.5%, 6.25%, and 3.125%. Wells with nematode eggs, having no metabolites, were considered as a negative control, while 0.025 mg/mL Oxfendazole (Zenith Pharma, Karachi, Pakistan), in 0.3% DMSO, served as a positive control. The plates were incubated at 37 °C for 24 h. A droplet of Lugol’s iodine was added to maintain the process for 24 h. Under 10× of an inverted microscope, the total number of hatched and unhatched eggs were counted. The experiment was replicated five times [
34].
The percent egg hatch inhibition was calculated as:
P test: number of unhatched or hatched eggs.
P total: number of unhatched or hatched eggs + Larvae (L1)
2.6. Genomic DNA Extraction
DNA from the abomasal bacteria were extracted by the standard protocol of the phenol chloroform method. Fresh bacterial broth cultures were centrifuged at 13,000 rpm for 5 min. The supernatant was discarded, and pellets were resuspended in 550 µL of Tris-EDTA buffer with the addition of 30 µL of 10% SDS and 5 µL Proteinase K. Vortexed properly and incubated at 37 °C for 1 h. After incubation, 100 µL of 5 M NaCl and 80 µL of CTAB/NaCl were added and mixed properly and incubated again at 65 °C in a water bath for 10 min. An equal volume of phenol, chloroform, and isoamyl alcohol (25:24:1) was added, mixed properly, and centrifuged at 13,000 rpm for 5 min to purify DNA. The supernatant was transferred to a 1.5 mL fresh Eppendorf tube. To this tube, an equal volume of chloroform and isoamyl alcohol, was added and centrifuged at 13,000 rpm for 5 min. The supernatant was transferred to a 1.5 mL Eppendorf tube, and for the precipitation of DNA, 0.6 volume of chilled isopropanol was added and placed at −20 °C for 20 min. DNA was pelleted by centrifugation at 13,000 rpm for 5 min and washed the pellet with 70% ethanol, and then dried at room temperature. Finally, DNA was dissolved in 50 µL Tris-EDTA buffer overnight incubation at 37 °C. The DNA concentration was measured using a spectrophotometer by taking absorbance at 260 nm and diluted for polymerase chain reaction (PCR).
2.6.1. DNA Confirmation and 16S RNA Amplification
The purified genomic DNA was verified through gel electrophoresis by mixing 4 µL genomic DNA with 2 µL loading dye and then load it in 1% agarose gel. The gel was run in a gel tank for 30 min at 120 volts and observed under UV transilluminator for DNA band. The amplification of the 16S RNA gene, universal primers, as shown in
Table 1, were run on genomic DNA samples.
2.6.2. PCR Conditions
The PCR tubes were put in the thermal cycle. The amplification was performed, following the condition given in
Table 2.
2.6.3. Gel Electrophoresis for PCR Products
The PCR products were confirmed on 1.5% agarose gel in TBE buffer containing 3 µL of ethidium bromide and run for 30 min at 100 voltages and 300 milli Ampere current. The bands were visualized by the Gel Doc system [
35].
2.7. Statistical Analysis
The information acquired from the bioassays, i.e., adult nematode mortality, nematode larval mortality, and eggs hatch inhibitions assays, were evaluated by P Test via Statistic version 9.
4. Discussion
Haemonchus contortus has a great financial significance causing serious disease and death of cattle and ruminants [
2]. Resistance to the available antihelmintic drugs has become a severe threat to livestock production [
7]. To decrease the use of chemical anthelmintics, an alternative method is a biocontrol by using bacteria and fungi against the nematode parasites.
Duddingtonia flagrans is as wide as nematophagous fungi, which is being explored to regulate intestinal nematodes in livestock [
32].
Bacillus thuringiensis is one of the most commonly used bacterial antagonists in biological control of
H. contortus that may promote insecticidal crystal proteins, commonly used to control pests and also due to its low mammalian toxicity [
23].
The current study tried to explore the bacterial abilities to reduce the population of
H. contortus at eggs, larval and adult stages. Bacterial isolates were collected from the abomasum of small ruminants. Different bacterial culture filtrate concentrations (100%, 50%, 25%, 12.5%, 6.25%, and 3.125%) were prepared and applied on three life stages of
H. contortus to observe the mortality of adult, larvae, and egg hatch inhibition. Higher concentration 100% and 50% of
C. testosteroni,
C. jiangduensis, and
P. weihenstephanesis showed 100% nematode eggs hatch inhibition. To our knowledge, these bacterial isolates have never been used against
H. contortus. Some researchers worked on the effect of
Bacillus thuringiensis on various life stages of
H. contortus [
30]. Earlier reports of leaf ethyl acetate and methanol extract of
A. squamosa,
E. prostrata,
S. torvum, and
C. roseus and acetone extract of
T. chebula showed more consistent results on egg hatch inhibition of
H. contortus [
36].
Previous studies showed the larvicidal effect of various species of Bacillus, such as
Bacillus circulans (Bcir),
B. thuringienisis var. osvaldocruzi (Bto),
B. thuringienisis var. israelensis (Bti), and
B. thuringienisis var. kurstaki (Btk) on L3 stage of
Haemonchus sp. among the tested bacteria,
B. circulans and
B. thuringienisis var. israelensis showed the best in vitro larvicidal efficiency of 90% and 94%, respectively, against the tested nematodes [
37]. In our research studies,
H. contortus larvae were treated with different bacterial metabolite concentrations, which cause 100% nematode mortality. These results are in line with the earlier reports on the control of nematodes in naturally infected sheep and goats, suggesting that the use of bacteria as an alternative control method for
H. contortus larvae [
21,
37].
In the case of egg hatch inhibition assay, the highest bacterial culture filtrates of
C. testosteroni and
C. jiangduensis at 100% and 50% bacterial metabolite concentration, resulted in 100% inhibition of
H. contortus eggs. The extract of the
Annona muricata plant has also been used to inhibit the eggs hatch and mortality of
H. contortus larvae and adults [
38].
This study has extended the findings by showing that the tested bacteria species are effective against all stages of the nematode parasite. The metabolites of bacterial species C. testosteroni and C. jiangduensis showed a greater effect than filtrates, obtained from P. weihenstephanesis. Similarly, C. jiangduensis and C. testosteroni showed a higher mortality rate of L3 and adult nematodes as compared to P. weihenstephanesis. However, all the bacteria isolates showed a similar impact on eggs hatch inhibition. The positive control in all cases showed the maximum larva mortality, while the negative control exhibited no nematocidal activity at all. It was concluded that the larval and adult nematode mortality, as well as the nematode egg hatch inhibition, have a positive correlation with the doses or concentration of the metabolites, extracted from the bacterial isolates.